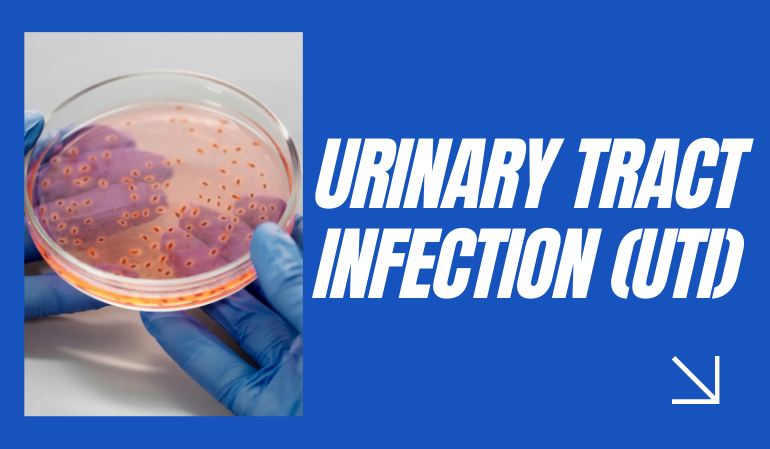
ostech image

+
Year experience


About Us
Dr. (Prof.) Sachin Kathuria
A highly regarded Consultant Urologist, Uro-Oncologist, Andrologist, and Robotic Surgeon with extensive experience in diagnosing and treating a wide spectrum of urological and male reproductive health conditions. He is dedicated to providing advanced, patient-centered care that blends modern medical technology with a compassionate approach.
- Areas of
Expertise:
- Pediatric Urology
- Male Infertility & Andrology
- Urethral Stricture Treatment
- Kidney Stone Management (ECIRS, Mini PERC, Laser Surgery)
- Laser Prostate Surgery (HoLEP/TURP)
- Prostate & Bladder Cancer Care
+
Successful
Surgeries

+
Years of
Experience

K
Happy
Patients

%
Patient
Satisfaction


Why Choose Us
Minimally Invasive,
Maximum Care
If you’re considering a robotic-assisted procedure, consult an experienced urologist like Dr. Sachin Kathuria, who combines cutting-edge technology with compassionate care to ensure the best results for his patients.

Advanced surgical excellence with a human touch.

Testimonial
What Customers are
Saying?
Dr. Sachin Kathuria treated my kidney stones with laser surgery. The procedure was painless, and I was back to normal in just a few days.
My father underwent laser prostate surgery under Dr. Kathurias care. His recovery was smooth, and we are grateful for the doctors support.
I had recurring urinary infections, but after consulting Dr. Sachin Kathuria, I finally received the right treatment and advice to stay healthy.
We consulted Dr. Kathuria for male infertility. His guidance and treatment plan made all the difference in our journey to parenthood.
Dr. Sachin handled my bladder cancer treatment with great expertise. His compassionate approach gave me strength throughout the process.
My son had a urinary problem, and Dr. Kathuria treated him with patience and care. We are truly thankful.
Undergoing prostate cancer surgery was daunting, but Dr. Sachin Kathurias expertise and confidence made me feel safe throughout.
My husband was treated for kidney cancer with minimally invasive surgery. Dr. Kathuria explained every step clearly and gave us full support.
I had a large kidney stone removed through laser surgery. Thanks to Dr. Kathuria, I experienced minimal pain and quick recovery.
Dr. Sachin Kathuria is not only a skilled urologist but also a very caring doctor. He listens patiently and provides the best treatment.

Blog
Latest News & Articles from
the Blog Posts
Robotic Urology Surgery – The Future of Minimally Invasive Care
Medical science has advanced rapidly over the last two decades, and urology is one field that has benefited the most fro...
Read moreKidney Stones: Causes, Symptoms, and Latest Treatment Options
Kidney stones are one of the most common urological problems affecting millions of people worldwide. While they can occu...
Read moreProstate Problems in Men Over 40 – What You Need to Know
The prostate is a small gland in men, located just below the bladder, that plays a crucial role in the reproductive syst...
Read more

Kidney Stone Treatment
Kidney Stone Treatment




